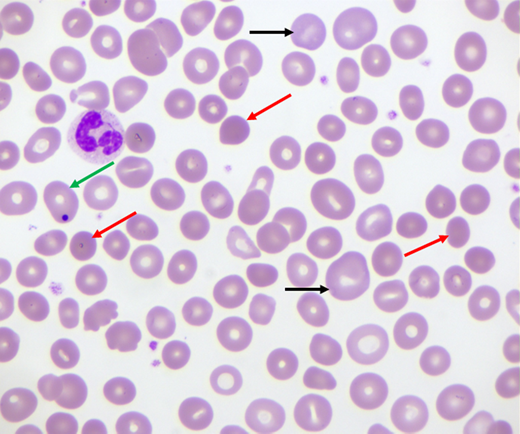
Peripheral blood smear in patient with wAIHA failing splenectomy. Increased numbers of spherocytes (red arrows) and polychromatophilic reticulocytes (black arrows), as well as one RBC with a Howell-Jolly body (green arrow), are indicated.

Abstract
Warm autoimmune hemolytic anemia (wAIHA) is characterized by evidence of red blood cell (RBC) hemolysis and a direct antiglobulin test positive for IgG and sometimes complement. While varying with the extent of the compensatory increase in RBC production, symptoms of anemia predominate, as does jaundice, the latter often exacerbated by concurrent Gilbert's syndrome. Initial treatment with corticosteroids is highly effective, with over 85% of patients responding but with less than one-third maintaining that response upon weaning. Subsequent rituximab administration in those failing corticosteroids provides complete remission in over 75% of patients and may be long-lasting. Over 50% of patients failing rituximab respond to erythropoiesis-stimulating agents or immunosuppressive agents. Splenectomy is best deferred if possible but does offer long-term remission in over two-thirds of patients. A number of new treatments for wAIHA (fostamatinib, rilzabrutinib, and FcRn inhibitors) show promise. A treatment algorithm for wAIHA is proposed to avoid the excessive use of corticosteroids.
Learning Objectives
Recognize the clinical and laboratory features that determine the diagnosis and etiology of wAIHA
Create a pathophysiology-based framework for the treatment of wAIHA with current and future novel therapies
CLINICAL CASE
A 69-year-old woman who was a Jehovah's Witness presented with profound fatigue. Her previous complete blood cell count (CBC) had been normal. Laboratory tests showed the following values: hemoglobin (Hgb), 6 g/dL; reticulocytes, 15%; lactate dehydrogenase (LDH), 560 IU/L; total bilirubin, 2.3 mg/dL; and haptoglobin, less than 10 mg/dL. The smear showed spherocytes, and the direct antiglobulin test (DAT) was strongly positive for immunoglobulin G (IgG) and weak for C3. She was treated with folate, 1 mg/d, and prednisone, 60 mg/d, for 3 weeks. Her LDH and bilirubin decreased nearly to normal, and her Hgb level rose to 13 g/dL, so prednisone was weaned over the next 8 weeks to 5 mg/d. Her Hgb level remained stable at 10 g/dL for 2 months on 5 mg of prednisone every other day but then dropped to 7 g/dL. Prednisone was increased to 20 mg/d, and 375 mg/m2 rituximab was administered weekly for 4 weeks, with a return of the Hgb to 12 g/dL. Steroids were again weaned to 5 mg/d, but 3 months later her Hgb level again dropped below 9 g/dL. Mycophenolate (MMF) at 1000 mg twice a day was started and the prednisone was weaned off, with Hgb levels remaining stable at 10 g/dL for 12 months. The patient developed increasing nausea, and the MMF was discontinued, with the Hgb level falling slowly to 7.7 g/dL 10 weeks later. The patient refused splenectomy, resumed prednisone at 5 mg/d, and was started on 200 mcg of darbepoetin alpha every 3 weeks, with Hgb rising to 10.5 g/dL (the prednisone having been tapered off). After 9 months, her insurance disallowed the darbepoetin alpha, and the patient again resumed prednisone at 5 mg/d. The Hgb level rose to 9.4 g/dL. She entered a clinical trial with fostamatinib and has been maintained on 150 mg twice a day for 2 years with an Hgb level of 12 g/dL off prednisone.
Introduction
The normal red blood cell (RBC) survives in the circulation for approximately 120 days (Figure 1A). Hemolytic anemia is considered when RBC survival drops below 100 days.1 In evaluating a patient for hemolytic anemia, it is important to first provide evidence for hemolysis. In patients with hemolysis, a number of laboratory tests become abnormal (Figure 1B). The reticulocyte count and reticulocyte index usually increase as a reflection of the increased egress of young RBCs from the bone marrow as they “shift” into the circulation. The destruction of RBCs results in the release of their LDH, and sometimes Hgb, into the circulation. Free Hgb may be detectable in the urine and serum and can bind to and reduce levels of haptoglobin; once filtered by the kidney, it may be catabolized by renal tubular cells, which retain iron and produce a positive urine hemosiderin test. The catabolism of RBCs increases bilirubin; the formation of bilirubin and the concurrent production of carbon monoxide in this process are perhaps the most accurate indicators of RBC turnover.2,3
RBC production and catabolism in states of normal (A) or accelerated (B) RBC turnover. The RBC half-life of 5 to 10 days is simply illustrative. The changes denoted in RBC production and markers of catabolism vary with the extent of RBC turnover.
RBC production and catabolism in states of normal (A) or accelerated (B) RBC turnover. The RBC half-life of 5 to 10 days is simply illustrative. The changes denoted in RBC production and markers of catabolism vary with the extent of RBC turnover.
The above attributes of hemolysis have many exceptions and nuances. As discussed below, the reticulocyte count and index may be low in many patients with autoimmune hemolytic anemia (AIHA) due to antibodies binding the reticulocyte or nutritional or bone marrow deficiencies. Given that Gilbert's disorder affects 5% to 10% of the Caucasian population,2 even mild hemolysis may result in strikingly elevated bilirubin and symptomatic jaundice. In general, the presence of urine hemosiderin, urine, or serum free Hgb reflects intravascular hemolysis, whereas increased LDH, reduced haptoglobin, and elevated bilirubin may be seen in both intravascular and extravascular hemolysis.
The documentation of RBC hemolysis is critical for the diagnosis of hemolytic anemia. In a small study of 100 anemic patients, a haptoglobin lower than 25 mg/dL was 83% specific and 96% sensitive and had a predictive value of 88% for hemolysis.4 When the haptoglobin level is less than 25 mg/dL and the LDH level is greater than the upper limit of normal, sensitivity drops to 50%, but specificity and predictive value are 100%.5 Hemolytic anemia is imprecisely defined as an anemia with shortened RBC survival, an LDH level greater than the upper limit of normal, and a haptoglobin level less than the lower limit of normal.1
Many regulatory mechanisms may affect the physiological compensation for increased RBC destruction. These include erythropoietin and nutrients such as folic acid, B12, and iron, as well as the general health of the bone marrow. Normal RBC production can increase 5-fold to 8-fold and provide significant compensation for reduced RBC survival. Indeed, for some patients with any type of mild hemolytic anemia, the provision of adequate nutritional resources and erythropoietin may allow adequate compensation with no need for other treatment.
There are many causes of hemolytic anemia. As described in Table 1, they include intrinsic defects of the RBC membrane, enzymes, or Hgb. Many disorders extrinsic to the RBC may also cause shortened RBC survival. Nonimmune mechanisms such as disseminated intravascular coagulation, infection, and oxidative stress are common. The immune mechanisms causing AIHA are much less common but are characterized by the demonstration of specific antibodies and/or complement binding to RBCs.
Types of hemolytic anemia
| Intrinsic | Membrane/cytoskeletal abnormalities— hereditary spherocytosis Enzyme defects—G6PD, pyruvate kinase deficiency Hgb defects—thalassemia, sickle cell disease |
| Extrinsic | |
| Nonimmune | Increased shear—artificial valves DIC, TTP, HUS Infection—malaria, babesiosis Oxidative stress—dapsone, rasburicase Liver failure—spur cell anemia Hypersplenism |
| Immune | AIHA Cold antibody—cold AIHA: cold agglutinin disease, cold agglutinin syndromea Warm antibody—wAIHAb Mixed |
| Intrinsic | Membrane/cytoskeletal abnormalities— hereditary spherocytosis Enzyme defects—G6PD, pyruvate kinase deficiency Hgb defects—thalassemia, sickle cell disease |
| Extrinsic | |
| Nonimmune | Increased shear—artificial valves DIC, TTP, HUS Infection—malaria, babesiosis Oxidative stress—dapsone, rasburicase Liver failure—spur cell anemia Hypersplenism |
| Immune | AIHA Cold antibody—cold AIHA: cold agglutinin disease, cold agglutinin syndromea Warm antibody—wAIHAb Mixed |
Intravascular hemolysis.
Extravascular hemolysis.
DIC, disseminated intravascular coagulation; G6PD, glucose-6-phosphate dehydrogenase deficiency; HUS, hemolytic uremic syndrome; TTP, thrombotic thrombocytopenic purpura.
Critical to the diagnosis of AIHA is the identification of antibodies against RBC antigens. This is routinely done using many variations of the test originally designed by Robin Coombs.6,7 RBCs are initially assessed for the presence of both immunoglobulin and C3 using polyspecific antisera.8 If positive, further assessments with antibodies specific for IgG and C3 are performed. A complete assessment of RBCs testing positive for IgG includes determining whether eluate autoantibodies react against multiple RBC types. The conclusions from the direct antiglobulin test (DAT) and eluate (using the DAT) are as follows:
| DAT and eluate results . | Conclusions . |
|---|---|
| C3 only | Immune complex, cold agglutinin disease, cold agglutinin syndrome |
| IgG, negative eluate | Drug, absorbed IgG |
| IgG, eluate specific | Alloimmune |
| IgG, eluate binds all RBCs | wAIHA, drug |
| IgG, +/− C3, eluate binds all RBCs | wAIHA |
| DAT and eluate results . | Conclusions . |
|---|---|
| C3 only | Immune complex, cold agglutinin disease, cold agglutinin syndrome |
| IgG, negative eluate | Drug, absorbed IgG |
| IgG, eluate specific | Alloimmune |
| IgG, eluate binds all RBCs | wAIHA, drug |
| IgG, +/− C3, eluate binds all RBCs | wAIHA |
In summary, AIHA is characterized by evidence of hemolysis and a positive Coombs test. Eighty percent of patients have an IgG (warm antibody) that binds to protein antigens on RBC surfaces at the core body temperature. Twenty percent of patients have an IgM (cold antibody) that binds to polysaccharide antigens on RBC surfaces at temperatures below the core body temperature. A small proportion of patients may have both (mixed AIHA).
The rest of this review focuses on warm AIHA (wAIHA).
Pathophysiology of wAIHA
More than 95% of patients with wAIHA have an IgG antibody that binds to RBC antigens independently of temperature. Rarely, antibodies may be IgA and even less commonly, IgM; these may account for the approximately 5% of patients who have “Coombs-negative” wAIHA. These antibodies are polyclonal even in clonal disorders such as chronic lymphocytic leukemia (CLL).9 About one-third fix complement; IgG1 and IgG3 fix complement more efficiently than the others.
The antibodies bind two major RBC antigens (Figure 2). About 40 000 Rh proteins are fixed to the cytoskeleton in each RBC and do not have a high enough density to activate complement. In contrast, there are about 800 000 glycophorin proteins A, B, C, and D fixed to the membrane of each RBC, a high enough density to activate complement.
Once bound to an antibody, the RBC can undergo multiple fates. Most will be bound to splenic macrophages via the FcγRIII receptor, resulting in either phagocytosis of the entire RBC or, more likely, removal of a significant portion of the RBC membrane-producing spherocytes (also called microspherocytes) (Figure 3). Unlike the normal RBC, spherocytes are not deformable and, upon entering the splenic Cords of Billroth, undergo destruction. This may account for some of the increased LDH and depressed haptoglobin seen in a disorder commonly described as “extravascular.” About one-third of patients with wAIHA additionally have complement bound to RBCs, and these C3b-coated RBCs are then cleared by the C3b receptors on hepatic Kupffer cells. In some of these RBCs, C3b is inactivated to C3d, thereby preventing their subsequent destruction and allowing a population of antibody/complement-coated RBCs to persist.
Peripheral blood smear in patient with wAIHA failing splenectomy. Increased numbers of spherocytes (red arrows) and polychromatophilic reticulocytes (black arrows), as well as one RBC with a Howell-Jolly body (green arrow), are indicated.
Peripheral blood smear in patient with wAIHA failing splenectomy. Increased numbers of spherocytes (red arrows) and polychromatophilic reticulocytes (black arrows), as well as one RBC with a Howell-Jolly body (green arrow), are indicated.
In summary, wAIHA is defined by the following: (1) evidence of hemolysis; (2) an IgG antibody binding to protein antigens on the RBC surface at the core temperature (warm antibody), demonstrated by a positive Coombs test for IgG in 95% of patients; (3) spherocytes on the peripheral blood smear. RBCs from 30% of patients bind both IgG and C3, and less than 5% are Coombs negative.1,10
Presentation of wAIHA
The presenting characteristics are variable. The typical symptoms of anemia are often present, including shortness of breath with exercise, generalized fatigue, dizziness, syncope, malaise, chest pressure/pain, and cognitive dysfunction. Most patients have a reduced health-related quality of life.11 Some patients with mild anemia and significant compensation have no symptoms.
Symptoms specific to hemolysis include jaundice, splenomegaly, and gallstones. Significant icterus may be present, even with mild hemolysis, in patients who have concurrent Gilbert's syndrome.2
Some wAIHA patients simply have a mild anemia and increased mean corpuscular volume and are referred to hematology for assessment for possible myelodysplastic syndrome. The increased mean corpuscular volume is related to the increased numbers of reticulocytes (which are generally larger than more mature RBCs) and is not due to a primary bone marrow disorder.
Incidence of wAIHA
As with many rare diseases, estimates of the epidemiology of wAIHA in adults are inexact. The incidence in adults ranges from 1.77 per 100 000 in Denmark to 2.4 per 100 000 in France, with a prevalence in Denmark of 17 per 100 000.12,13 The median age of presentation in adults is 53 years and 60% are female.14 The disease incidence increases with age, with 0.35 per 100 000 patient-years in those more than 20 years old; 0.51 per 100 000 patient-years in those 20 to 50 years old, and 3.34 per 100 000 patient-years in patients over 50.15
Causes of wAIHA
Table 2 lists the many causes for wAIHA.14,16 Infections and a wide variety of drugs/toxins are commonly associated with wAIHA, but these hemolytic events are mostly transient, usually identified upon initial evaluation, and resolve with treatment of the underlying infection or discontinuation of the associated drug/toxin. What is of concern then in this discussion are those patients in whom wAIHA is chronic and not obviously associated with transient infection or drug/toxin exposure. As listed in Table 2, some patients nonetheless have some infection or some drug/toxin exposure not initially identified. More commonly, about half of patients have no apparent underlying cause. About a quarter have an identifiable lymphoproliferative disease (LPD); as high as 11% of patients with CLL develop wAIHA, with this number increasing after exposure to fludarabine.17 Another quarter of all patients have an identifiable immune/autoimmune disorder, such as common variable immune deficiency, systemic lupus erythematosus, Sjogren's syndrome, or autoimmune hepatitis. Although 29% of immune thrombocytopenia (ITP) patients have a positive DAT, few have active hemolysis.18 Evans syndrome has an incidence of 1.8 per 1 000 000 patient-years, with the wAIHA and ITP often not concurrent.19
Causes of chronic wAIHA
| Idiopathic: ~45% |
| Malignancies: LPDs: ~24% |
| 11% of CLL patients |
| Even higher after fludarabine treatment |
| Immune disorders: ~25% |
| Immune deficiency disorders (common variable immune deficiency) |
| Autoimmune disorders (systemic lupus, ulcerative colitis) |
| ~10% of patients with systemic lupus |
| ITP patients (Evans syndrome) |
| Others: ~5% |
| Viral infection (usually kids) |
| Drugs (huge number) |
| Idiopathic: ~45% |
| Malignancies: LPDs: ~24% |
| 11% of CLL patients |
| Even higher after fludarabine treatment |
| Immune disorders: ~25% |
| Immune deficiency disorders (common variable immune deficiency) |
| Autoimmune disorders (systemic lupus, ulcerative colitis) |
| ~10% of patients with systemic lupus |
| ITP patients (Evans syndrome) |
| Others: ~5% |
| Viral infection (usually kids) |
| Drugs (huge number) |
Evaluating the patient for wAIHA
History
The initial evaluation of the patient should include a review of the signs and symptoms of anemia, the prior bouts of such, and the presence of jaundice or dark-colored urine. A personal or family history of other autoimmune conditions is not uncommon. Symptoms of LPD such as adenopathy, night sweats, and splenomegaly should be sought. At this point it is also of paramount importance to assess for recent infections (eg, babesiosis) and exposure to medications or toxins. Evidence of blood loss ought to be considered. Assess for symptoms of venous thromboembolism.
Physical examination
Signs of significant anemia such as pallor, tachycardia, heart failure, pulmonary edema, and peripheral edema may be present. Asymmetric lower-extremity edema should raise concern for thrombosis. Icterus, particularly of the sclera, is commonly found. While mild splenomegaly is common, the spleen is usually not enlarged enough to be appreciated by palpation. The presence of significant splenomegaly on palpation associated with adenopathy should raise the concern of an LPD.
Laboratory examination
Table 3 lists the laboratory assessments of patients with wAIHA. A CBC and a reticulocyte count and tests to measure LDH, bilirubin, and haptoglobin identify those with hemolytic anemia. The DAT and eluate assessment confirm whether this is a wAIHA. A review of the peripheral blood smear is mandatory to affirm the presence of spherocytes and assess for LPDs. Subsequent tests for underlying causes include antinuclear antibody and rheumatoid factor to assess for autoimmune causation and a serum protein electrophoresis to assess for chronic variable immune deficiency, as well as flow cytometry and often a chest/abdomen/pelvic computed tomographic scan looking for LPD. Only in the presence of features (lymphadenopathy, other cytopenias, other abnormalities on the peripheral blood smear) suggestive of other hematologic disorders or in cases of Coombs-negative wAIHA is bone marrow examination indicated. In those with Coombs-negative AIHA, a bone marrow examination helps document accelerated erythropoiesis and may exclude other primary bone marrow disorders. Measurement of levels of nutrients and erythropoietin assess for adequacy of bone marrow compensation. Although their role in predicting thrombotic risk has not been demonstrated, this reviewer routinely checks D-dimer and a prothrombin fragment.
Recommended laboratory tests for chronic wAIHA
| CBC with differential . | Folate level . |
|---|---|
| Reticulocyte count | Erythropoietin levela |
| Review blood smear | Serum protein electrophoresis |
| Haptoglobin | ANA, rheumatoid factor |
| Bilirubin (direct/total) | Flow cytometry for clonal B cellsa |
| LDH level | Chest/abdomen/pelvic CT scan |
| Coombs test and eluate assessment | (Bone marrow examination)b |
| Fe/total iron-binding capacity/ferritin | Prothrombin fragment 1.2a |
| B12 level | D-dimer |
| CBC with differential . | Folate level . |
|---|---|
| Reticulocyte count | Erythropoietin levela |
| Review blood smear | Serum protein electrophoresis |
| Haptoglobin | ANA, rheumatoid factor |
| Bilirubin (direct/total) | Flow cytometry for clonal B cellsa |
| LDH level | Chest/abdomen/pelvic CT scan |
| Coombs test and eluate assessment | (Bone marrow examination)b |
| Fe/total iron-binding capacity/ferritin | Prothrombin fragment 1.2a |
| B12 level | D-dimer |
If testing available.
In certain situations (see text).
ANA, antinuclear antibody; CT, computed tomographic.
Treatment of wAIHA
Who should be treated?
Some patients with minimal anemia are sufficiently compensated for their hemolysis and may not require any therapy. Such asymptomatic patients usually have Hgb level higher than or equal to 10 g/dL and might experience a reduced quality of life with therapy. These patients are followed closely, supplemented with folate, and advised to contact their hematologist should they experience signs of worsening hemolysis (eg, darker urine, more icterus, worsening fatigue), especially when stressed by infection or other medical problems. Generally, patients who need treatment are symptomatic, have Hgb levels lower than 10 g/dL, or require RBC transfusion.
In patients with wAIHA secondary to symptomatic LPDs or immune/autoimmune disorders, therapy directed at the underlying disorder may mitigate the hemolysis.
What are the goals of therapy for wAIHA?
While desirable, normalization of Hgb is rarely required. Successful therapy strives for a stable Hgb level over 10 g/dL, resolution of symptoms, and transfusion independence. Treatment should minimize the adverse effects of immunosuppression. In particular, it is important to avoid the side effects of corticosteroids, with chronic prednisone dosage never exceeding 5 mg/d and avoided entirely if possible. Although splenectomy may be a definitive treatment for many, most patients prefer to avoid it; joint decision-making in wAIHA is mandatory.
For clinical trials, the First International Consensus Meeting defined a “response” as an increase in Hgb by more than 2 g/dL or normalization of Hgb without a biochemical resolution of hemolysis, along with an absence of transfusion for the last 7 days.1 A complete response (CR) was defined as normalization of Hgb, no evidence of hemolysis (normal bilirubin, LDH, haptoglobin, and reticulocytes), and the absence of transfusions.
What is the initial therapy for wAIHA?
Corticosteroids are the initial therapy for almost all patients (Table 4). In patients with significant symptomatic anemia, RBC transfusion needs to be considered. All patients should be supplemented with folic acid of at least 0.4 mg/d and repleted with B12 and iron if so deficient.
Treatments for chronic wAIHA
| RBC transfusion |
| Adequate nutritional support |
| Folate, B12, iron |
| Reduce antibody production |
| Corticosteroids 1 mg/kg/d |
| Rituximab |
| MMF |
| Azathioprine |
| Cyclophosphamide |
| Cyclosporine |
| Danazol |
| Alemtuzumab |
| Daratumumab |
| Reduce macrophage function |
| Corticosteroids |
| Splenectomy |
| Intravenous immunoglobulin |
| Vincristine |
| Increase RBC production |
| ESAs |
| RBC transfusion |
| Adequate nutritional support |
| Folate, B12, iron |
| Reduce antibody production |
| Corticosteroids 1 mg/kg/d |
| Rituximab |
| MMF |
| Azathioprine |
| Cyclophosphamide |
| Cyclosporine |
| Danazol |
| Alemtuzumab |
| Daratumumab |
| Reduce macrophage function |
| Corticosteroids |
| Splenectomy |
| Intravenous immunoglobulin |
| Vincristine |
| Increase RBC production |
| ESAs |
RBC transfusions
In medically unstable, symptomatic patients, particularly those with Hgb levels lower than 6 g/dL, RBC transfusion is indicated. Appropriately crossmatched blood may not be immediately available because of the panagglutinin, and therefore type-specific blood is used. In general, worsening of hemolysis is more likely to occur with alloimmune antibodies than with autoantibodies.
Corticosteroids
Prednisone at 1 mg/kg/d for 2 to 4 weeks until the Hgb level is over 10 is a common starting dose.20,21 Although dexamethasone is sometimes used, this reviewer finds its effects to be transient and cannot recommend its use. Over 85% of patients have a rise in Hgb.22,23 Slow steroid tapering over 5 to 12 weeks to the lowest effective dose is then undertaken, with close monitoring (every 1-2 weeks) of Hgb, reticulocyte count, LDH, and haptoglobin. Pneumocystis carinii pneumonia prophylaxis should be considered in patients who are maintained at prednisone doses over 20 mg/d for over 1 month. Unfortunately, with steroid tapering, the initial high response is not maintained: 50% maintained response at 3 months but only 31% to 38% at 12 months. Overall, nearly two-thirds of corticosteroid responders require additional therapy.22
In patients failing to respond rapidly or for those presenting with severe disease, the addition of rituximab should be considered (see below).
Subsequent treatments for wAIHA
Although most patients have a significant response to corticosteroids, with tapering most patients lose their response and require additional therapy. The many current therapy options are listed in Table 4, and the most common are discussed separately next.
Rituximab
Rituximab is highly effective in patients resistant to or dependent upon corticosteroids. Standard doses of 375 mg/m2 weekly for 4 weeks or 2 doses of 1000 mg 2 weeks apart have been studied. When added to corticosteroids, the response rate is much higher than with corticosteroids alone. In one study, response rates of 75% to 80% at 12 months with mostly CRs (defined as a normal Hgb level on no treatment) were reported; the CR rate with corticosteroids was only 36%.20 The response duration was more than 36 months in 70% of patients. In a second smaller phase 3 study, overall responses at 1 year were 31% (95% CI, 11.0-58.7; 5 CR) for prednisone alone versus 75% (95% CI, 47.6-92.7; 11 CR, 1 partial remission [PR]) for prednisone plus rituximab.21 After 2 years, 10 in 16 rituximab patients but only 3 in 16 placebo patients maintained a CR (P = 0.011).21 Eighteen wAIHA patients in a third study were treated with a brief course of corticosteroids plus 100 mg of rituximab weekly for 4 weeks. All patients responded by 6 and 12 months with approximately 70% CR24 ; relapse-free survival at 36 months was 76%.25
Splenectomy
Although often declined by patients, splenectomy is an effective treatment for wAIHA.26,27 Laparoscopic approaches are preferred. Presplenectomy vaccination is recommended if there is adequate time. Deep vein thrombosis (DVT) prophylaxis for up to a month following treatment should be considered. CR rates of 75% have been reported in one study and of 81% at 3 years in another. 26,27 Long-term complications of infection and thrombosis need to be considered. Shared decision-making is encouraged.
Intravenous immunoglobulin
As with most treatments for wAIHA, there are little data. Intravenous immunoglobulin doses of 0.4 g/kg/d for 5 days have been studied. In 73 patients the overall response rate was 29 in 73 (40%).28 A 2-g/dL Hgb rise in 2 weeks was seen in 25 of 62 (40%), and a Hgb rise over 2 g/dL in 2 weeks with a Hgb higher than 10 g/dL was seen in 9 of 61 (15%) patients. The treatment response was short-lived.
Mycophenolate
Doses of 500 to 1000 mg of MMF twice a day have been studied. This drug may take 4 to 8 weeks before reaching its full effect. Pooled data from 2 short series show that all 8 patients responded with a significant rise in Hgb.29,30 MMF is well tolerated except for mild nausea and remains the favorite immunosuppressive drug for this reviewer.
Cyclophosphamide
Azathioprine
wAIHA is not uncommon in dogs; 87 of 93 dogs responded to azathioprine and survived.33 In humans, doses of 100 to 200 mg daily have been used, with reported response rates of 26 of 33 (79%) in 2.2 months in one study and 7 of 8 (1 CR, 6 PR) in another.23,32 With discontinuation of the drug, 42% relapsed.32 To avoid severe hematological toxicity, patients need to be screened for deficiencies of thiopurine methyltransferase.34
Erythropoiesis-stimulating agents
Approximately 20% to 40% of patients with AIHA have a reduced reticulocyte response due to antibodies against reticulocytes or reduced erythropoiesis; this correlates with a poor response. In a recent multicenter prospective study, 51 patients with wAIHA had severely reduced erythropoietin levels compared with other forms of anemia; they were treated with an erythropoiesis-stimulating agent (ESA) beginning at a median (range) of 24 (0.03-187) months from diagnosis.35 The overall response rate (Hgb >10 g/dL or ≥2 g/dL increase in the absence of transfusions) was 55% at 15 days, 71% at 30 days, 73% at 3 months, 76% at 6 months, and 78% at 12 months. The median (range) Hgb rise at 6 months was 2.1 (0-2.18) g/dL.
Other agents
Individual case reports and small retrospective analyses have reported therapeutic responses to danazol, cyclosporine, bortezomib, daratumumab, vincristine, eculizumab, and alemtuzumab.
Complications of wAIHA and their treatment
Aside from the well-known complications of long-term corticosteroid treatment, 3 other aspects of wAIHA warrant brief comment:
Patients face an increased risk of developing LPDs. An LPD developed in 7 of 71 (10%) of patients with wAIHA after a median (range) of 26.5 (9-76) months, suggesting that wAIHA might be the first manifestation of a nascent LPD.36
Patients' risk of thromboembolism (venous more than arterial) is increased. In a recent study, 15 of 126 (12%) patients developed thrombosis.37 Increased LDH and transfusions were associated with increased risk. Thrombosis is of particular concern following splenectomy38 ; appropriate postoperative DVT prophylaxis should be provided. Hospitalized patients should receive routine DVT prophylaxis.
Monitoring for diabetes is impaired. Given the reduced red cell survival, hemoglobin A1c levels do not provide accurate glucose monitoring.39
Newer therapies in development for wAIHA
wAIHA is a frustrating disorder, and many patients remain on inappropriately high doses of corticosteroids for years. Newer therapies are needed.40
Immunoproteasome inhibitors such as bortezomib and KZR–616 may reduce autoantibody formation, as might CD38 inhibitors such as daratumumab. Drugs that block the neonatal Fc receptor shorten IgG half-life and reduce anti-RBC antibody.40 Inhibitors of mediators of phagocytosis such as syk kinase (fostamatinib) and Bruton kinase (rilzabrutinib) are currently being studied.41,42 Fostamatinib increased Hgb to a level above 10 g/dL, with an increase of 2 g/dL in 11 of 24 (46%) refractory wAIHA patients; Hgb improvement was often seen after 2 weeks and was maintained with few adverse events.43 Clinical trials are also underway to assess the efficacy of inhibitors of complement factors C1 and C3.
Putting it all together
A proposed treatment algorithm can be found in (Figure 4). As in this case, the initial therapy for most patients should be corticosteroids, usually in the form of prednisone at 1 mg/kg/d. If the patient is severely affected or shows no response within 2 weeks, rituximab should be given at a dose of either 375 mg/m2 for 4 weeks or 2 separate weekly doses of 1000 mg each. Corticosteroids are weaned slowly over 8 to 12 weeks, and if an adequate therapeutic response (eg, Hgb over 9-10 g/dL) cannot be maintained at a dose of prednisone less than or equal to 5 mg/d, rituximab (if not already given) is administered. If an adequate therapeutic response is not obtained after 2 or 3 months, our preferred approach is 1000 mg of MMF twice a day in those who have demonstrated a strong corticosteroid response. In those having never had an adequate corticosteroid response or failing MMF, an ESA, such as 200 mcg of darbepoetin alfa every 2 weeks, is administered for several months in those with an endogenous erythropoietin level under 500 mIU/mL. Throughout this treatment algorithm, the lowest effective dose of prednisone is administered to maintain an adequate Hgb response; prednisone tapering is undertaken whenever another therapeutic modality demonstrates a beneficial effect. In patients refractory to low-dose corticosteroids, rituximab, immunosuppressive agents, and ESAs, we reassess the diagnosis and indications for treatment. Our subsequent preference is for clinical trials, such as those with fostamatinib, rilzabrutinib, or a neonatal Fc receptor inhibitor. While not averse to splenectomy, this is usually reserved for those highly refractory to the therapeutic modalities described above and for whom clinical trials are not appropriate.
Acknowledgment
I am pleased to thank Dr Drew Provan for the artistry in Figure 2 and the Visual Abstract.
Conflict-of-interest disclosure
David J. Kuter: research funding: Argenx, Biocryst, Immunovant, Rigel, Sanofi (Principia), Takeda (Bioverativ), UCB; consultancy: Alexion (Syntimmune), Amgen, Argenx, BioCryst, Bristol Myers Squibb, Caremark, Cellphire, Cellularity, CRICO, Daiichi Sankyo, Hengrui, Immunovant, Incyte, Kyowa-Kirin, Merck Sharp Dohme, Momenta, Novartis, Pfizer, Platelet Biogenesis, Platelet Disorder Support Association, Rigel, Sanofi (Bioveratif), Sanofi (Genzyme), Sanofi (Principia), Sobi (Dova), Takeda, UCB, Up-To-Date; stock ownership: Rubius.
Off-label drug use
David J. Kuter: none of the pharmacologic therapies listed have received regulatory approval for the treatment of wAIHA.